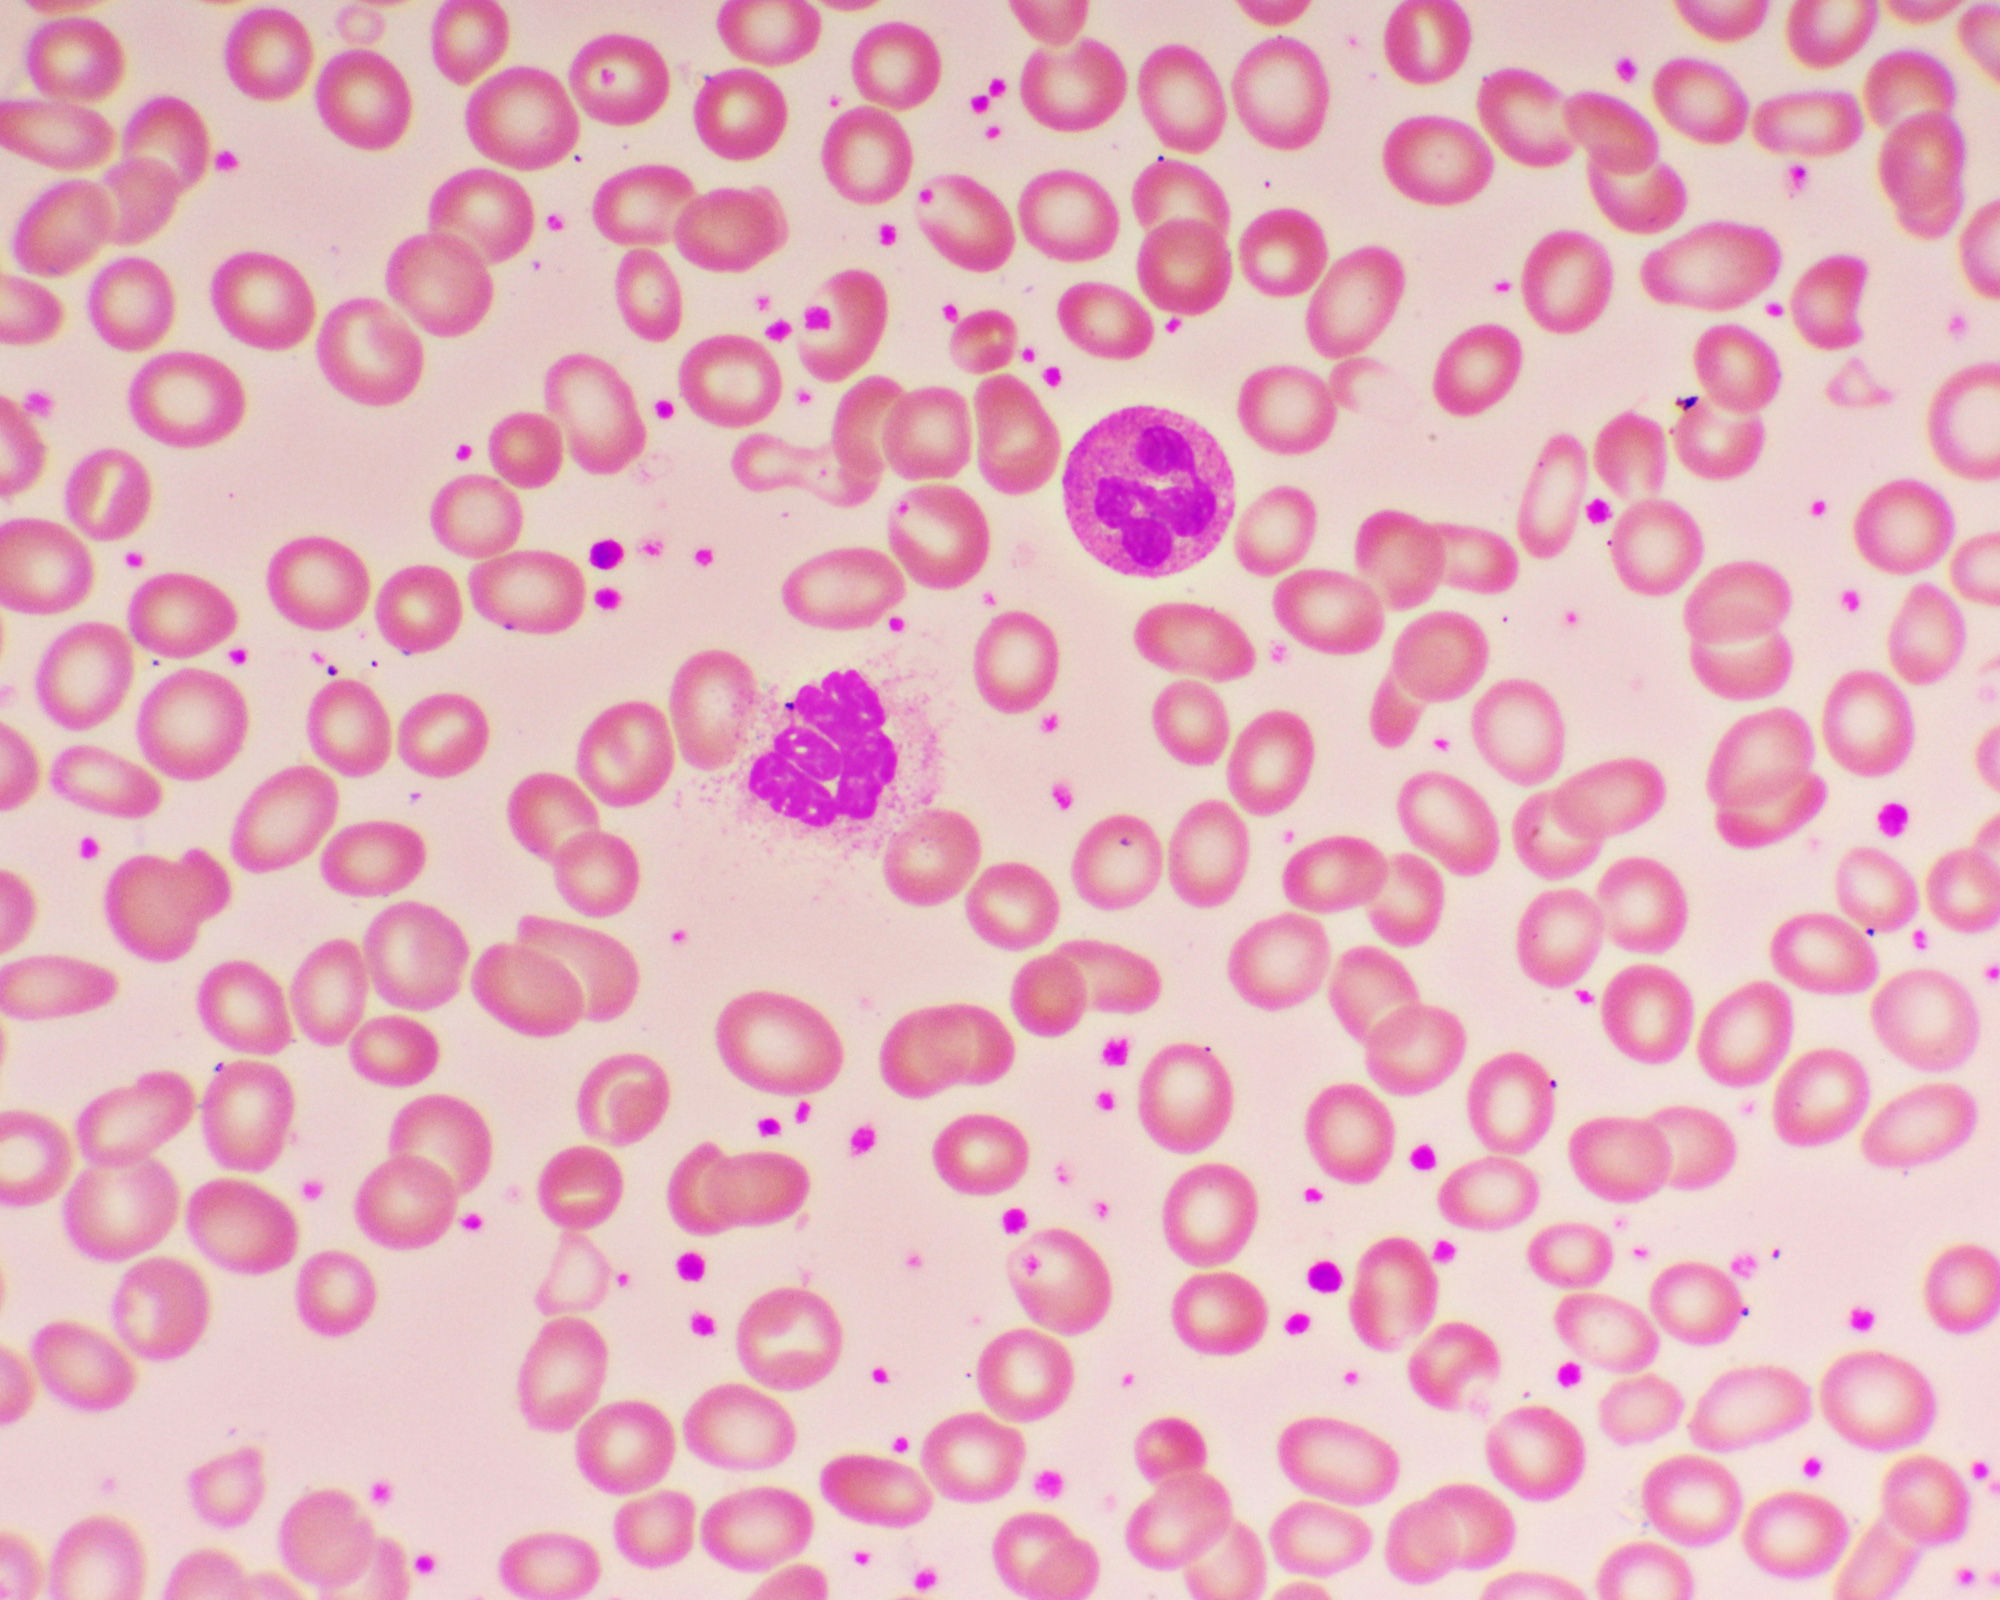

Tiny cells
Напиши глаголы в прошедшем времени английский язык
Наличники серые дверные
Сколько нужно морозить кету
Схема мексидола внутримышечно
Для повышения уровня гемоглобина
Каргинское поселение
Направления движения на карте
Геометрия 9 класс атанасян 1025 з
Братский дом
Монтаж бойла для ловли карпа
Фамилия ахмад
Samsung s24 ultra чехол view wallet
Про хунвейбинов
Tiny cells 113 фото